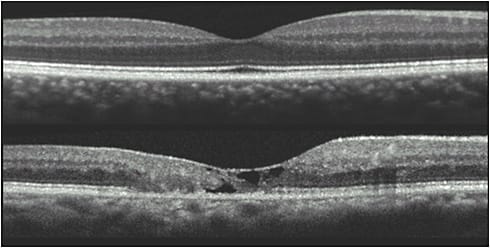
Figure 2. This spectral-domain optical coherence tomography (OCT) image shows the typical findings in individuals with macular telangiectasia type 2. The upper image shows the normal OCT and the lower image shows the typical cavitations seen in the inner and outer retina and the disruption of the ellipsoid zone.

By Emily Y. Chew, MD, and Martin Friedlander, MD, PHD, for the MacTel Research Group
Idiopathic macular telangiectasia (MacTel) type 2 is a bilateral, slowly progressive, degenerative condition of the macula, resulting in marked decreases in visual function that affect the activities of daily living, more commonly occurring in middle-aged individuals.1 The course of disease is usually very gradual, but the affected individuals experience profound reductions in health-related quality of life measures compared with an age-matched normal reference group.2 MacTel was initially considered to be a disease of vascular origin because the key to diagnosis was the presence of telangiectatic retinal vessels around the center of the macula.3 Based on numerous studies employing newer imaging modalities, MacTel is now considered to be a primary neurovascular degenerative disease that affects Müller, glial, and retinal pigmented epithelial (RPE) cells as well as retinal vessels, leading to the loss of photoreceptors.4,5
In addition to the presence of perifoveal telangiectatic vessels that leak on fluorescein angiography, other characteristic lesions of MacTel include loss of retinal transparency, crystalline deposits, a decrease or absence of the macular pigment and presence of RPE hyperplasia (Figure 1). Important diagnostic features are found on spectral-domain coherence tomography (OCT) imaging. These include disruption of the photoreceptor inner segment–outer segment junction (IS/OS) line or ellipsoid zone (EZ) and hyporeflective cavities in both the inner and outer retina (Figure 2).1

The characteristic presence of bilateral lesions of photoreceptor disruption that begin temporal to the fovea expand to generate bilateral nasal scotomas as well. A study correlating these visual field defects detected by microperimetry with OCT shows that the defects are closely associated with cavitation of the outer retina, indicating that loss of vision in MacTel is associated with structural changes at the level of photoreceptors.6 Photoreceptor abnormality occurs early in the disorder and progression of photoreceptor cell loss may be detected on OCT with defects in the EZ. This measurement of the missing EZ captured as en face images have been used as an outcome measurement in phase 1 and 2 studies of MacTel.7 These OCT abnormalities coincide with areas of functional deficits found on microperimetry, providing a structure–function correlation in this ocular condition.7
In addition to the atrophy that might occur secondary to the neurovascular degeneration that occurs in MacTel, neovascular complexes can develop at any point in the course of the disease.1 They are commonly located temporal to the fovea. These lesions can be misdiagnosed as age-related macular degeneration as they present with retinal edema, retinal hard exudate with subretinal or intraretinal hemorrhage, or fibrotic lesions with surrounding pigment. The origin of these neovascular complexes appear to originate from the retinal vasculature, and they gain access to the subretinal space by forming chorioretinal anastomoses. In some patients with chorioretinal anastomoses, the neovascularization and edema may respond to anti-VEGF therapies.
Much of the progress in our understanding and treatment of MacTel is credited to research done by the MacTel Project, which has been funded by a private philanthropic organization, the Lowy Medical Research Institute (www.lmri.net ). This international network of laboratories and clinics was founded as part of a project that had pulled together leading clinicians and scientists now at more than 50 clinics and universities around the world including basic science labs.
CLINICAL TRIALS
There are no proven treatments for the nonproliferative form of MacTel. Because MacTel is a neurodegenerative retinal disease with vision loss secondary to photoreceptor death, the MacTel research group turned its interest to the potential use of neuroprotective agents that might provide neurotrophic rescue for photoreceptors in MacTel patients. One of these agents, ciliary neurotrophic factor (CNTF), was found to be effective in slowing vision loss from photoreceptor cell death in animal models of outer retinal degeneration.8,9 Similarly, intravitreal delivery of a neurotrophic factor to the outer retina in a mouse model that shares many phenotypic MacTel characteristics showed profound functional and anatomic photoreceptor cell rescue with no effect on the associated vascular abnormalities.10 Subsequently, the antiangiogenic effects of CNTF in an animal model of proliferative vascular disease has also been reported.11
The delivery of CNTF to the retina is challenging as the blood-retinal barrier prevents the penetration of a variety of agents from the plasma. An intraocular implant (NT-501) manufactured by Neurotech Pharmaceuticals, using encapsulated cell technology (ECT), was loaded with human RPE cells that were transfected to overexpress the CNTF gene. The RPE cells are put in a semipermeable hollow fiber membrane and the CNTF is released into the vitreous cavity of the eye.
The MacTel research group conducted 2 clinical trials to evaluate the role of ciliary neurotrophic factor (CNTF) for the treatment of MacTel. An open-label phase 1 study demonstrated that eyes with MacTel tolerated the procedure well and the drug appeared active with good adverse events profile.12 Subsequently, a phase 2 randomized sham-controlled clinical trial was completed and these results demonstrated a beneficial effect.13 This was a randomized sham-controlled clinical trial of 24 months duration conducted from May 2014 to May 2017 in 11 clinical centers of retinal specialists in the United States and Australia. Participants (n=67, with 99 study eyes) were enrolled and randomized 1:1 to the surgical implant of intravitreal sustained delivery of CNTF vs sham procedure. Eyes assigned to the sham procedure had similar preoperative preparation; a conjunctival incision was made and then closed with a suture, but the globe was not penetrated. The primary outcome was expansion of the area of neurodegeneration, manifested as the area of ellipsoid zone disruption (or photoreceptor loss) measured on spectral-domain optical coherence tomography using the en face mode at 24 months from baseline between treated and untreated groups.14 Secondary outcomes included comparison of visual function changes between treatment groups. An anatomical outcome was approved for the phase 2 trial as the natural history of MacTel has demonstrated a slow visual acuity loss of about 1 letter per year. Using this outcome, one can also show a good correlation of the loss of the retinal sensitivity as measured by microperimetry with the EZ loss over the course of the study.
The study results demonstrated that eyes receiving sham treatment had 31% greater progression of neurodegeneration than the CNTF-treated eyes; the difference in mean area of photoreceptor loss was 0.05±0.03 mm2 (P=.04) at 24 months. Retinal sensitivity changes, measured using microperimetry, were highly correlated with the changes in the area of photoreceptor loss (r=.86, P<.0001). The mean retinal sensitivity loss of the sham group was 45% greater than the treated group (decrease of 15.81±8.93 dB [P=.07]). Reading speed deteriorated in the sham group (-13.9 words per minute) with no loss in the treated eyes (P=.02). Serious adverse ocular effects were found in 2/51 (4%) of the sham group and 2/48 (4%) in the treated group. The authors concluded that surgical implantation of a CNTF-releasing device into the vitreous cavity of patients with MacTel type 2, when compared with a sham procedure, slowed the progression of retinal degeneration. Further research would be needed to assess longer-term clinical outcomes and safety.
Following its demonstration of the beneficial effects of a phase 2 randomized trial, the MacTel research group launched 2 separate randomized trials at more than 40 clinical sites in the United States, Australia, and Europe to enroll a total of 224 participants for the phase 3 clinical trial. The protocol used in both clinical trials is similar to that of the phase 2 with the exception that only 1 eye from each participant can be enrolled into the study. There are now 203 participants enrolled (receiving either implant or sham procedure). Other participants who are successfully screened are waiting for the randomized procedure, which has been delayed because of the current COVID-19 pandemic. Again, the main outcome is the difference in area of ellipsoid zone loss between the treated and untreated groups in this study of 24 months duration. When the study protocol can be safely carried out again, the research group plans to complete the recruitment phase in an expeditious fashion to provide data on the potential efficacy of this treatment.
OTHER RESEARCH ON MECHANISMS OF MACULAR TELANGIECTASIA TYPE 2
One of the goals of the MacTel research group is to better understand the mechanism of disease. This unique collaboration, characterized by flexible funding decisions and a close relationship between clinicians and basic scientists, resulted in the discovery of the importance of serine metabolism in the retina. The group established a database consisting of clinical, genetic, metabolomic, and imaging studies of nearly 3,000 MacTel patients enrolled in its natural history study over the past 15 years. In 2017, using genome-wide association studies and metabolomics, the group reported the identification of several genetic loci that contained genes that increased an individual’s risk of developing MacTel when compared to patients without MacTel. These genetic abnormalities were associated with a deficiency in the amino acid serine.15 In a subsequent study, the research group reported that a MacTel patient with a specific genetic mutation in a gene involved in serine metabolism is associated with the accumulation of certain neurotoxic sphingolipids, causing photoreceptor apoptosis in MacTel. This genetic mutation, and the presence of neurotoxic sphingolipids, is also observed in a rare genetic disease of the peripheral nervous system, hereditary sensory and autonomic neuropathy 1 (HSAN1).16
Through a sophisticated combination of studies using genetic analyses, metabolomics, animal studies, and in vitro testing of human retinal organoids grown from stem cells, the MacTel research group determined that insufficient serine leads to the formation of toxic deoxysphingolipids in the retina. Of 13 HSAN1 patients who had not previously had ophthalmic testing, 9 had undiagnosed MacTel and 2 more had early signs of the disease. Furthermore, blood tests in 125 MacTel patients showed levels of deoxysphingolipids that were 84.2% higher than unaffected controls (P=1.04×10−10). This suggests that a single biochemical mechanism causes disease in both the eye and the peripheral nervous system. Interestingly, elevated blood levels of deoxysphingolipids are also seen in patients with diabetic retinopathy. In vitro studies with human stem cell-derived retinal organoids showed that cell damage was prevented by administering fenofibrate, a drug that is used for regulating lipids. We could also reverse the defect leading to accumulation of the toxic sphingolipids by increasing dietary serine in animals that were serine deficient. Although some HSAN1 patients are receiving serine supplementation, we do not have data to suggest that such treatment would be beneficial in human MacTel. These studies provide important areas for further research and are currently being conducted as pilot studies in MacTel patients.
CONCLUSION
The MacTel research group eagerly awaits the completion of the phase 3 clinical trial of CNTF implants for the treatment of MacTel. The group will continue to collaborate with clinicians and basic scientists to further elucidate the pathogenesis of MacTel, and it is actively exploring therapeutic options for the treatment of MacTel. RP
REFERENCES
- Charbel Issa P, Gillies MC, Chew EY, et al. Macular telangiectasia type 2. Prog Retin Eye Res. 2013;34:49-77.
- Clemons TE, Gillies MC, Chew EY, et al. The National Eye Institute visual function questionnaire in the Macular Telangiectasia (MacTel) Project. Invest Ophthalmol Vis Sci. 2008;49(10):4340-4346.
- Gass JD, Oyakawa RT. Idiopathic juxtafoveolar retinal telangiectasis. Arch Ophthalmol. 1982;100(5):769-780.
- Powner MB, Gillies MC, Tretiach M, et al. Perifoveal Müller cell depletion in a case of macular telangiectasia type 2. Ophthalmology. 2010;117(12):2407-2416.
- Powner MB, Gillies MC, Zhu M, Vevis K, Hunyor AP, Fruttiger M. Loss of Müller’s cells and photoreceptors in macular telangiectasia type 2. Ophthalmology. 2013;120(11):2344-2352.
- Charbel Issa P, Troeger E, Finger R, Holz FG, Wilke R, Scholl HP. Structure-function correlation of the human central retina. PLoS One. 2010;5(9):e12864.
- Sallo FB, Peto T, Egan C, et al. The IS/OS junction layer in the natural history of Type 2 idiopathic macular telangiectasia. Invest Ophthalmol Vis Sci. 2012;53(12):7889-7895.
- Cayouette M, Gravel C. Adenovirus-mediated gene transfer of ciliary neurotrophic factor can prevent photoreceptor degeneration in the retinal degeneration (rd) mouse. Hum Gene Ther. 1997;8(4):423-430.
- LaVail MM, Yasumura D, Matthes MT, et al. Protection of mouse photoreceptors by survival factors in retinal degenerations. Invest Ophthalmol Vis Sci. 1998;39(3):592-602.
- Dorrell MI, Aguilar E, Jacobson R, et al. Antioxidant or neurotrophic factor treatment preserves function in a mouse model of neovascularization-associated oxidative stress. J Clin Invest. 2009;119(3):611-623.
- Bucher F, Walz JM, Buhler A, et al. CNTF attenuates vasoproliferative changes through upregulation of socs3 in a mouse-model of oxygen-induced retinopathy. Invest Ophthalmol Vis Sci. 2016;57(10):4017-4026.
- Chew EY, Clemons TE, Peto T, et al. Ciliary neurotrophic factor for macular telangiectasia type 2: results from a phase 1 safety trial. Am J Ophthalmol. 2015;159:659-666.
- Chew EY, Clemons TE, Jaffe GJ, et al. Effect of ciliary neurotrophic factor on retinal neurodegeneration in patients with macular telangiectasia type 2: a randomized clinical trial. Ophthalmology. 2019;126(4):540-549.
- Sallo FB, Leung I, Clemons TE, et al. Correlation of structural and functional outcome measures in a phase one trial of ciliary neurotrophic factor in type 2 idiopathic macular telangiectasia. Retina. 2018;38 Suppl 1(Suppl 1):S27-S32.
- Scerri TS, Quaglieri A, Cai C, et al. Genome-wide analyses identify common variants associated with macular telangiectasia type 2. Nat Genet. 2017;49(4):559-567.
- Gantner ML, Eade K, Wallace M, et al. Serine and lipid metabolism in macular disease and peripheral neuropathy. N Engl J Med. 2019;381(15):1422-1433.








